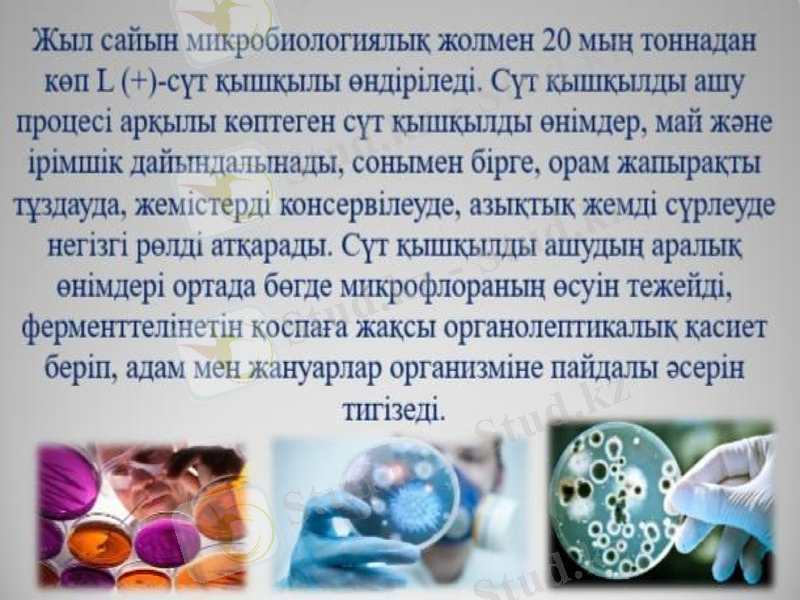
Slide 13

Ашыту процесі: тарихы, түрлері, фазалары, микроорганизмдері және тағам өндірісіндегі қолданылуы



Тақырып: Ашыту процесі

Жоспар:
Ашу үрдісі туралы түсінік және ашу түрлері.
Ашыту микроорганизмдері
Ашу фазалары
Ашытуға негізделген тағам өндірісі

Қазақшаlike

Ферменттер қатысатын процестерді ғылыми тұрғыдан зерттеу ХVІІ ғасырдың орта кезінен басталды. Осы кезде Гельмонт қанты бар сұйық заттардың ашуы ерекше қоздырушылар көмегімен жүретіндігін анықтаған. Осыдан кейін А. Лавуазье ашу кезінде қант түгелдей көмірқышқыл газға және спиртке айналатындығын анықтады.

Кейінірек, 1810 жылы Гей-Люссак бұл тұжырымдарды келесі химиялық реакцияда қорытындылады:
C6H12O6 (глюкоза) → 2CO2 (көмірқышқыл газы) + 2C2H6O (этанол)
Алайда, көптеген жылдар бойы ферменттеу кезінде байқалған бұл химиялық өзгерістер ыдырайтын заттар, яғни өлі жасушалар шығаратын молекулалық дірілдің өнімі деп тұжырымдалды.
Қарапайым сөздермен айтқанда: барлық зерттеушілер ашыту кейбір организмдердің өлімінің жанама әсері және тірі организм үшін қажет процесс емес екеніне сенімді болды.

Луи Пастер спирттік ашу процесін зерттеп мындай қорытындыға келеді:ашу процесін жүргізетін химиялық заттар емес, ашытқының яғни тірі клеткалардың тіршілік әрекеті болып табылады.

Ашыту процесі дегеніміз не?
Ашыту- бұл органикалық субстраттың анаэробты өзгеруін (оттексіз) қарапайым органикалық қосылыстарға айналуын, оттегінің араласуынсыз ферментативті жүйелермен метаболизденуі мүмкін емес химиялық процесс.

Ашу өнімдеріне жатады:
органикалық қышқылдар (сүт, май, сірке, құмырсқа) ;
спирттер (этил, бутил, пропил), ацетон;
СО2 мен Н2 жатады.

Ашытудың 5 түрін атап өтуге болады:
алкогольдік ашыту
сүт немесе сүт қышқылын ашыту
пропионды ашыту
май қышқылы
Аралас қышқылды ашыту

Ашуту процесіне қатысатын микроорганизмдер
Тамақ өнеркәсібінде Lactobactericeae, Bacillaceae, Mycobactericeae тұқымдасының өкілдері биообъект ретінде пайдаланады.
Lactobactericeae тұқымдасының жататын түрлері көбінесе сүт пен сүт тағамдарында кезедеседі. Бұл бактериялар сүт құрамындағы қантпен қоректеніп сүт қышқылын түзеді. Ал сүт қышқылы сүтті ашытып айранға айналдырады. Сондықтан оларды сүт қышқылы бактериялары деп атайды. Бұл бактериялардың өнеркәсіп пен ауыл шаруашылығында маңызы зор.


Acetobacter

Ұйытқы (инокулят) -микробиологиялық құрамы бар, ашуға алып келетін қоспа. Сүт өндірісінде ұйытқыларды сүт-қышқылды өнімдерді алуға қолданады (соның ішінде йогурт, айран, простокваша), қамыр және сусындарды (атап айтқанда сыра, квас алуға) қолданады. Ұйытқылар қатты және сұйық болып бөлінеді.

Сүт қышқылды өнімдерді алу үшін келесі ұйытқылар алынады:
Мәйек ферментінен) ;
Саңырауқұлақ ашытқыларынан - Болгар таяқшасы (Lactobacillus bulgaricus), ацидофиль таяқшасы (Lactobacillus acidophilus), сүт қышқылды стрептококк (Streptococcus salиvarиus subsp. thermophиlus) т. б;

Ашытқылар - бір жасушалы, мицелийлері жоқ, бүршіктенетін саңырауқұлақтар. Олар аскомицеттер класына жатады. Жасушаларының формасы сопақ, дөңгелек, лимон тәріздес болып келеді. Олардың жасушаларының қабығы, цитоплазмасы және боялмаған препараттарда айқын көрінетін ядросы болады. Жас жасушалардың цитоплазмасы біркелкі, ал ересектерінде вакуольдер пайда болады.
Ашытқылардың құрылымы бактериялардың құрылымына ұқсамайды: олар сопақ немесе ұзынша болып бактериялардан ірілеу келеді, олардың көлемі 10 мкм. -ға жетеді. Олар бөлініп, бүршіктеніп, қолайлы жағдайда ұрықтану (споралар) арқылы көбейеді.

Ашу процесінің ашытқылардың қатысымен жүретінін 1837 жылы Каньяр Дела Тур, ал Ашу. табиғатын 1857 жылы Л. Пастер сынды француз зерттеушілері дәлелдеген, 1897 жылы неміс химигі Э. Бухнер қанттың Ашуы ашытқы клеткаларынан алынған сөлдердің әсерімен де жүретінін көрсеткен. Бұл көптеген ферменттерді бөліп алуға мүмкіндік берді.
Аскомицеттер:
Saccharomycotina
Taphrinomycotina
Schizosaccharomycetes
Базидиомицеттер:
Urediniomycetes
Sporidiales

Ашытқы саңырауқүлақтардың систематикасы көбею тәсілдері мен физиологиялық қасиеттеріне негізделген. Олар екі түқымдасқа бөлінеді: сахаромицеттер және сахаромицет еместер.
Сахаромицеттер. Бұларға мәдени ашытқы саңырауқұлақтар жатады. Олар бүршіктену және споралар түзу арқылы көбейеді. Сондықтан бүларды нағыз ашытқы саңырауқүлақтар деп атайды. Мәдени ашытқы саңыраукүлақтарға нан, шарап, сыра ашытқы саңырауқүлақтары жатады.
Өндірісте, әсіресе олардың сахаромицес церевидзе және сахаро-мицес эллипсойдеус деген түрлерінің маңызы шарап өндірісінде қолданады.
Сахаромицет емес ашытқы саңырауқұлақтар негізінен жалған ашытқы саңырауқұлақтар. Олай аталатын себебі: ашытқы саңы-рауқұлақтарының спора түзуге қабілеті болмайды бүршіктену арқылы ғана көбейе алады. Бүлардын, көпшілігі әр түрлі өндірістердегі өнімдерді зақымдайды. Дегенмен олардың ішінде шаруашылық үшін маңызды туыстары бар. Олар: торула және микодерма. Торула туысына жататын ашытқы саңырауқүлақтар шар тәрізді келеді және ашыту процесі барысында азғана мөлшерде спирт түзеді. Торула кефир деп аталатын өкілі қымыз және кефир сияқты сүт тағамдарын даярлауда пайдаланылады

- Іс жүргізу
- Автоматтандыру, Техника
- Алғашқы әскери дайындық
- Астрономия
- Ауыл шаруашылығы
- Банк ісі
- Бизнесті бағалау
- Биология
- Бухгалтерлік іс
- Валеология
- Ветеринария
- География
- Геология, Геофизика, Геодезия
- Дін
- Ет, сүт, шарап өнімдері
- Жалпы тарих
- Жер кадастрі, Жылжымайтын мүлік
- Журналистика
- Информатика
- Кеден ісі
- Маркетинг
- Математика, Геометрия
- Медицина
- Мемлекеттік басқару
- Менеджмент
- Мұнай, Газ
- Мұрағат ісі
- Мәдениеттану
- ОБЖ (Основы безопасности жизнедеятельности)
- Педагогика
- Полиграфия
- Психология
- Салық
- Саясаттану
- Сақтандыру
- Сертификаттау, стандарттау
- Социология, Демография
- Спорт
- Статистика
- Тілтану, Филология
- Тарихи тұлғалар
- Тау-кен ісі
- Транспорт
- Туризм
- Физика
- Философия
- Халықаралық қатынастар
- Химия
- Экология, Қоршаған ортаны қорғау
- Экономика
- Экономикалық география
- Электротехника
- Қазақстан тарихы
- Қаржы
- Құрылыс
- Құқық, Криминалистика
- Әдебиет
- Өнер, музыка
- Өнеркәсіп, Өндіріс
Қазақ тілінде жазылған рефераттар, курстық жұмыстар, дипломдық жұмыстар бойынша біздің қор #1 болып табылады.



Ақпарат
Қосымша
Email: info@stud.kz